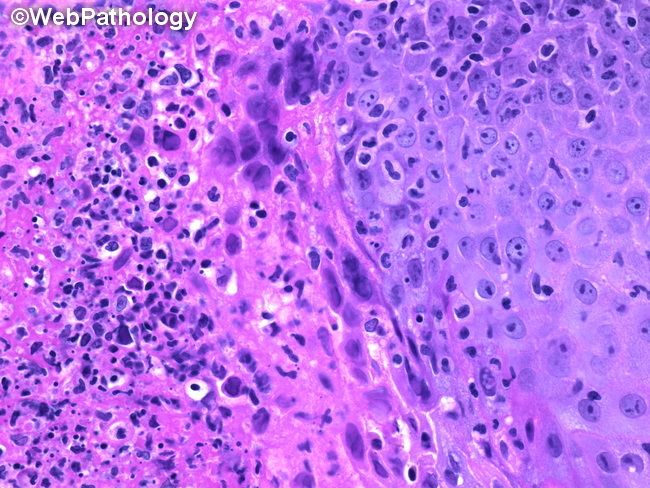

овой Герпес Фото
Половой Герпес Фото 36 фото
Осенний Призыв 2026 Картинки
Идеи Для Фото В Черном Платье
Легочное Сердце Фото
Фото Голых Жен Вк
Отделка Фасадными Панелями Фото
Картинки Не Разлей Вода
Фото Николаева В Инстаграм
Нации По Фото В Яндексе
Фото Летчика В Кабине Самолета
Приложение Которое Делает Человека На Фото Голым